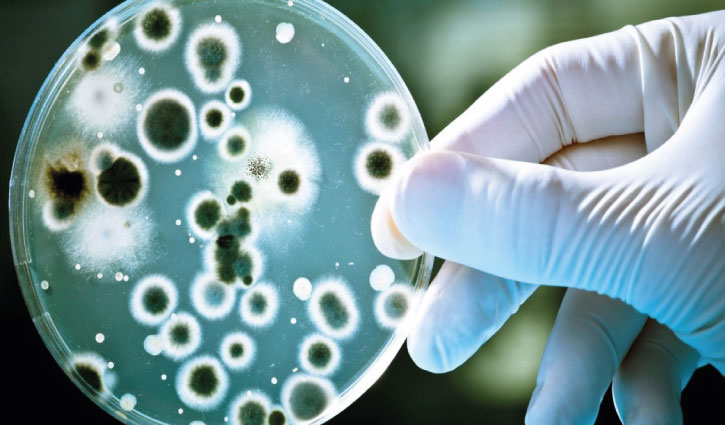

Non-Communicable Diseases: Definitions And Examples : Certainly! Non-communicable diseases (NCDs), also known as chronic diseases, are medical conditions or health issues that are not caused by infectious agents and cannot be transmitted from person to person. These diseases typically develop over a long period and are often associated with genetic, environmental, and lifestyle factors. Here‘s a detailed overview of some significant non-communicable diseases:

1. Cardiovascular Diseases:
- Coronary Artery Disease (CAD): A condition where the blood vessels that supply the heart.
- Hypertension (High Blood Pressure): A medical condition characterized by elevated blood pressure in the arteries.
2. Neurological Diseases:
- Alzheimer’s Disease: A progressive neurodegenerative disorder leading to cognitive decline and memory loss.
- Parkinson’s Disease: A disorder of the nervous system affecting movement due to a lack of dopamine in the brain.
3. Respiratory System Diseases:
- Asthma: Inflammation and narrowing of the airways, causing difficulty in breathing.
- Chronic Obstructive Pulmonary Disease (COPD): A lung disease, often caused by smoking, characterized by reduced airflow.
4. Metabolic Diseases:
- Obesity: Excessive accumulation of body fat, often associated with various health problems.
5. Cancer:
- Lung Cancer, Breast Cancer, Colorectal Cancer: Diseases characterized by uncontrolled cell growth and spread.
- Lung Cancer, Breast Cancer, Colon Cancer: They are a group of diseases that occur as a result of uncontrolled growth and spread of cells.
6. Mental Health Issues:
- Depression: A mood disorder causing a persistent feeling of sadness and loss of interest.
- Anxiety Disorders: Conditions marked by excessive worry and fear.
7. Rheumatological Diseases:
- Osteoarthritis: A degenerative joint disease resulting in the breakdown of joint cartilage.
- Rheumatoid Arthritis: An autoimmune disease causing inflammation and joint damage.
These diseases often result from a combination of genetic predisposition and modifiable . Prevention and management strategies typically involve promoting a healthy lifestyle, including regular physical activity, a balanced diet, avoiding .
Public health efforts globally aim to raise awareness about these non-communicable. the burden of these conditions on individuals and healthcare systems.
Click for more information!